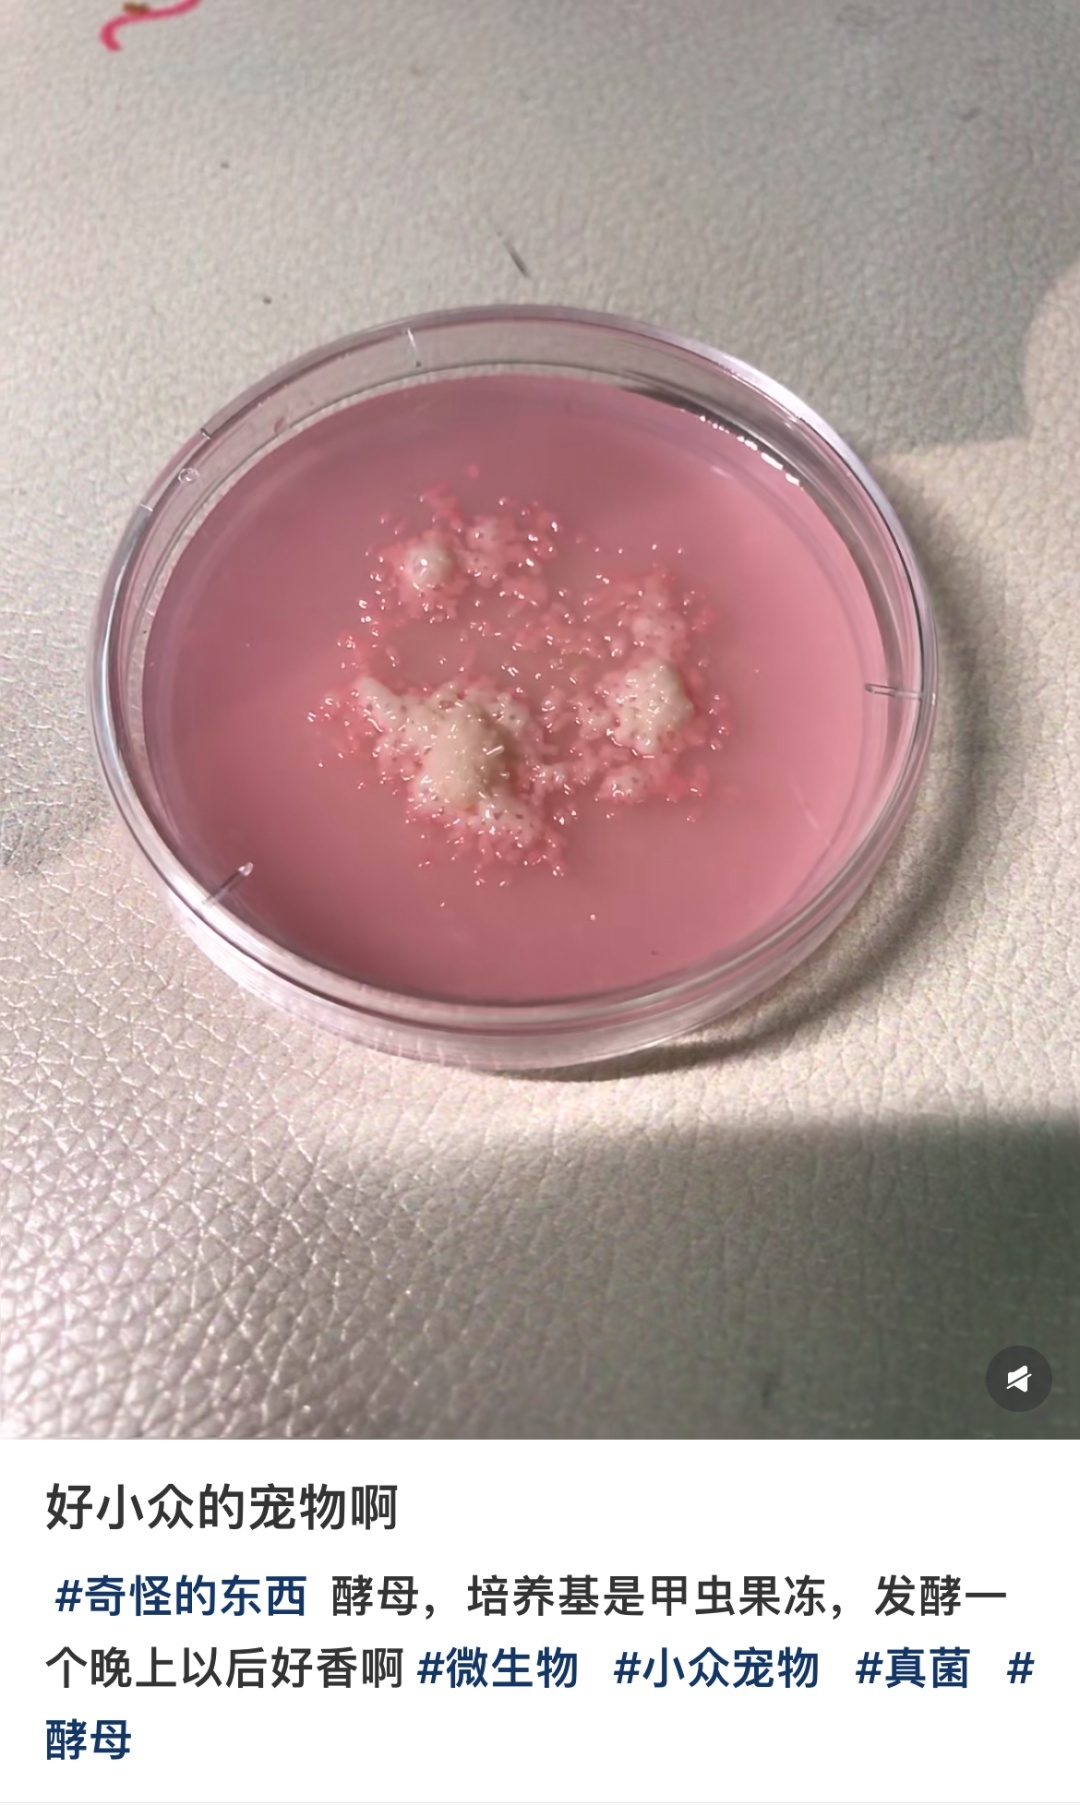

超市赶海?捞个宠物!

谁说赶海一定要去海边?
有人在家附近
就找到了新的好去处
↓↓↓
生鲜超市水产区
在瞬息万变的时代浪潮里,青年群体已然成为消费与文旅领域的先锋力量,他们的每一次选择,都在引领全新潮流。《YOUNG生活》栏目汇聚专业视角,展开全方位、深层次的探讨分析,为你呈上全面且深刻的洞察,助你深度理解青年群体的消费与文旅观念,轻松把握时代发展的新动向。通过阅读文章,把握消费动向,紧跟时代潮流,丰富谈资,拓宽视野,打破年龄与观念的壁垒,让青年群体实现更好的交流互动,共同拥抱这个充满活力的时代。
每一期,都是一次探索青年潮流生活的奇妙之旅,期待与你共赴这场精彩之约!
最懂生活的年轻人
流行下班后去超市“赶海”
随着生鲜超市的水产品类
日渐丰富
除了购买水产品做饭
大家在水产区能做的事情
也多了起来
例如——
想去水族馆
但工作繁忙怎么办?
不少人选择直奔商场
0元入场
“盒马鲜生水族馆”
“永辉水族馆”
“大润发水族馆”
彩虹鲷鱼、老鼠斑鲈
新西兰蓝鲍……
可可爱爱的水生生物
让人在紧凑生活的间隙
收获一丝“小治愈”
不仅如此
还有一批会玩的年轻人
竟然开始在商场“赶海”了
在某社交平台
关于“超市赶海”的话题浏览量
已超200万

那“赶海”
能收获什么?
有博主在给自家河豚买食物的时候,发现超市卖的新鲜扇贝上有几株活的海葵。她心生怜悯,就将它们放在自己的鱼缸里养着,还用虾肉精准投喂。
投喂快两周之后,海葵就快要从“小鼻嘎”变成“克苏鲁”了。


▲来源:网友@仙人钓鱼饭
在超市“赶海”捞宠物的网友
并非个例
他们收获的“宠物”
也形态各异
简直像是“开盲盒”
如西瓜海葵、樱花海葵
地毯海葵、纵条肌海葵等

▲来源:网友@耿直蘑菇蛋

▲网友@彗星阖斗 记录的海葵日常
运气好点还能碰上
豆蟹、藤壶、海鞘、管虫等
你永远不知道下一秒
能获得哪种随机掉落的惊喜

放进海缸里的生蚝壳
也可能自带惊喜
长出翠绿的“森林”
▲像极了海底小森林。来源:网友@屁屁
幸运的话
可能还会在超市里
偶遇稀有物种
或许你便宜淘回来
看起来很普通的螺
实际身价可能翻倍
有人就以14.9元的价格
买了一颗罕见颜色的脉红螺
市场价值
可达30元至100元不等

终于,年轻人的宠物
也开始变得抽象了
除了猫猫狗狗和爬宠
当代年轻人脑洞大开
开辟出宠物新赛道
01
养石头
社交平台上
不少网友分享
自家宠物石的照片和日常
它们有名字、还有个性
也支持MBTI鉴定

02
养芒狗
网友们将吃完的芒果核
清洗干净后吹蓬松
就得到一个毛茸茸的“小狗”

03
养“纸模”
上班族的新晋“桌搭”
小猪、小狗、小熊猫
派大星、愤怒的小鸟
甚至还有Hello Kitty

04
养牙膏、养酵母
“年轻人开始养酵母当宠物了!”
所谓养酵母
是将酵母装进容器内
控制温度与糖分
定期“喂食”面粉和水
观察其发酵动态
还有年轻人分享养牙膏的经历
其“饲养”方式同样简单
每天补充水分即可
对于以上奇奇怪怪的“宠物”
不少网友大赞非常好养
省事不闹心


还有一些网友表示大受震撼
同时认为人类虽然莫名其妙
但这正是AI取代不了的原因


年轻人万物皆可“养”?
专家解读:作为精神寄托是合理的
看似离谱的“新型宠物”,为啥会让年轻人着迷?
不少网友认为自己是在寻找“日常生活里的快乐瞬间”,他们把石头、芒果核等当成寄托,主打一个陪伴,期望在浮躁喧嚣的环境中,寻求内心的一份平静。
浙江大学医学院附属精神卫生中心抑郁障碍科医生尹肖雯认为,年轻人养宠是社会情绪的一种表现,“因为年轻人普遍比较孤独,他们在情感上渴望陪伴、被包容和接纳,宠物成了年轻人的情感慰藉。”
作为80后,尹医生说自己小时候也有属于那个年代的宠物。比如电子宠物,包括几年前流行的《旅行青蛙》,对年轻人来说都是低成本满足情感需求的一种方式。
有些人不仅喜欢养宠物,还喜欢给宠物取名字,给其穿衣打扮,甚至用自己小时候的小名。“实际上在悉心照顾宠物的过程中,把自己代入了。”尹医生说。当养猫养狗条件不允许的时候,年轻人可能会转向更为低成本的“宠物”。
▲网友@懒洋洋Mango的芒狗
站在医生的视角,尹医生支持年轻人养宠物。“现在年轻人主动照顾和施予别人的机会其实很少,在悉心照料宠物的过程中,可以收获付出的满足感,这也是一种收获。”

▲好好养,就会收获超级无敌可爱的小海葵,一天过去形态就能发生变化。来源:网友@✨✨✨✨✨✨
你有养宠物吗?
快来留言区晒出
你的“小可爱”吧
